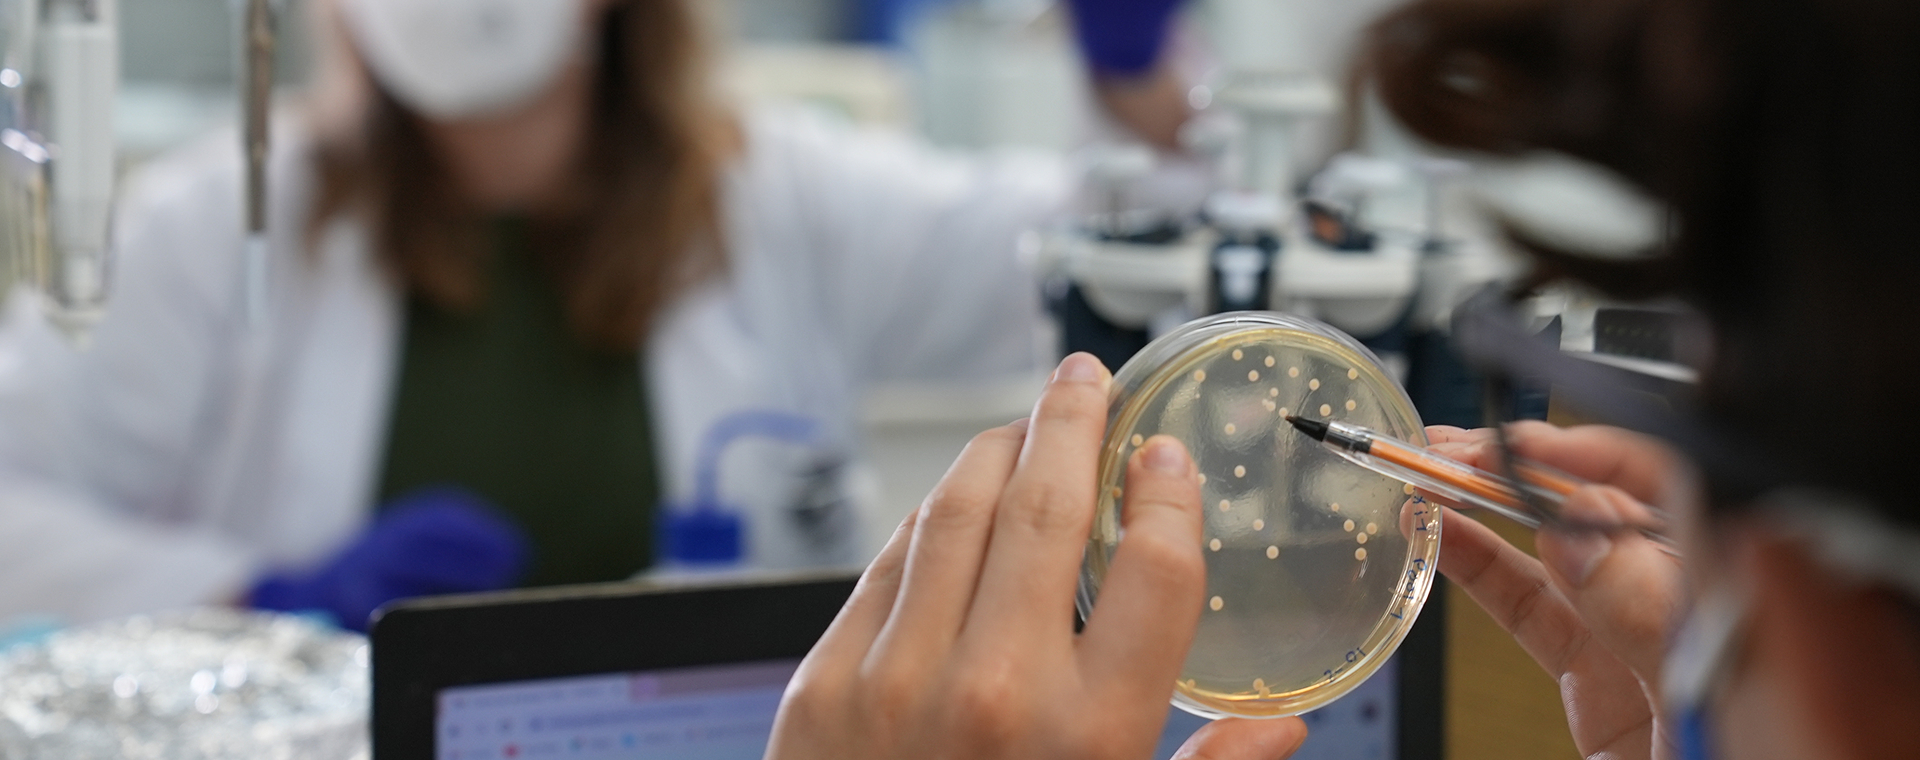

Boeing ecoDemonstrator program
Our flight demonstrators test and validate new technologies that improve safety and efficiency in airplanes and fleet operations






Compared to 747-400F




Our flight demonstrators test and validate new technologies that improve safety and efficiency in airplanes and fleet operations


The Boeing Cascade Climate Impact Model explores ways to improve efficiencies and reduce emissions as our industry grows.
Responsible aerospace begins inside our facilities because efficient operations cut costs, conserve resources and prevent pollution. We work to optimize building and equipment performance and utilize SAF in our operations.

We invest strategically in our site infrastructure to drive efficiency and reduce cost. And we prioritize LEED standards and implement renewable energy plans in support of our goals.

Boeing is committed to restoring legacy industrial sites to support economic and environmental well-being of local communities. We recognize our responsibility for past practices and work as a long-term partner to help repair damage. We coordinate with local governments and communities to make tangible progress for people, wildlife, and the environment.

Boeing’s current perspective on sustainability matters is reflected in the most recent Sustainability Report. Previous Sustainability Reports are included here for their historic value, consistent with Boeing’s culture of transparency and continuous improvement.

We’re shaping the future of sustainable aviation through research and innovative technology development.